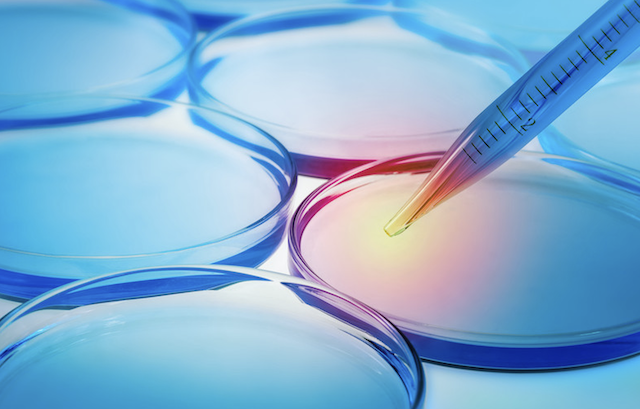

PRODUCTS

InSpace
内視鏡ワーキングチャンネル内検査スコープ
(Channel Inspection Scope for Gastro&Colonoscope)
消化器内視鏡のワーキングチャンネルの中を観察・検査する内視鏡です。
内視鏡のワーキングチャンネルの中に挿入する様々な医療機器が体内の
組織などをチャンネル内に引き込み、洗浄しても残存するバクテリアなどがバイオフィルムを構築。バイオフイルムは強固なため通常の洗浄方法では除去が困難です。この製品はチャンネル内にバイオフイルムが存在するか高画質で観察・検査ができます。
バイオフイルム除去剤「BAKU」/「BAKU PLUS」
医療器具や内視鏡のワーキングチャンネル内に存在するバイオフイルムを特殊な方法で除去する液剤です。
微生物は集合すると微生物を覆う物質(細胞外マトリクス)を生成し、細胞外マトリクスに守られた微生物集合体=バイオフィルムとなる。バイオフィルムは抗生物質や洗浄剤では簡単には除去することができず、細胞外マトリクスに守られて残存した病原菌が人体内に侵入し、感染症を引き起こす原因となります。BAKUはバイオフィルムの分散に有効な洗浄成分により、堆積したバイオフィルムやバイオファウリング成分を効率よく剥離します。
【製品特徴】
低起泡性です。
非殺菌性、非酸化性、中性液体のため取扱い時の安全性が高いです。
中性液体のため、部材を劣化させません。
広範囲のpH (pH3以上)で有効です。
殺菌剤と併用すると、殺菌効果の持続性を高めることができます。
【推奨用途】
BAKU:透析装置など
BAKU PLUS:内視鏡、その他医療機器